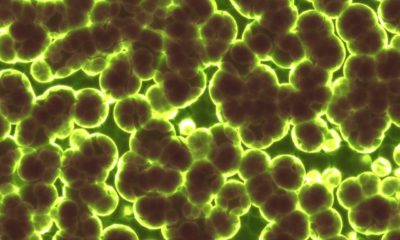

Все статьи с тегом "Антибиотики"
-
Лекарственные средства и препараты, медицинское оборудование«Скрытая» пандемия 21 века – эксперты об антимикробной резистентности
19 ноября 2021 года в рамках Всемирной недели правильного использования антимикробных препаратов состоялась пресс-конференция «Антимикробная резистентность –...
«PRO Здоровье» 06.12.2021 -
Лекарственные средства и препараты, медицинское оборудованиеЧем грозит необоснованное применение антибиотиков
C 18 по 24 ноября проходит Всемирная неделя правильного использования противомикробных препаратов (World Antibiotic Awareness Week).
«PRO Здоровье» 16.11.2021 -
Лекарственные средства и препараты, медицинское оборудованиеДля спасения жизней. Pfizer объявила о новых показаниях к применению антибактериального препарата Завицефта® у детей
Завицефта® – комбинированный препарат, действующими веществами которого являются авибактам и цефтазидим.
«PRO Здоровье» 02.06.2021 -
Еда, продукты питанияВселяет уверенность: почему экологичный подход набирает популярность
Все больше людей проявляют интерес к разумному потреблению – сортируют мусор, заменяют одноразовые товары на долгоиграющие аналоги,...
«PRO Здоровье» 21.04.2021 -
Лекарственные средства и препараты, медицинское оборудованиеДень Здоровья: вопрос устойчивости микроорганизмов к антибиотикам на повестке
Во Всемирный день здоровья компания BD (Becton Dickinson) привлекает внимание общественности к одной из наиболее серьезных угроз...
«PRO Здоровье» 07.04.2021 -
Лекарственные средства и препараты, медицинское оборудованиеЗачем нужны антибиотики и как их правильно принимать
О том, зачем нужны антибиотики и как их правильно принимать, рассказывает педиатр Европейского Медицинского Центра (ЕМС), врач...
«PRO Здоровье» 23.03.2021 -
Лекарственные средства и препараты, медицинское оборудованиеУроки пандемии: как сохранить возможности медицины в условиях антибиотикорезистентности
Антимикробная резистентность – устойчивость микроорганизмов к лекарственным препаратам – в настоящее время достигла масштабов эпидемии, но осведомленность...
«PRO Здоровье» 18.03.2021 -
Лекарственные средства и препараты, медицинское оборудованиеК 2050 г. более 10 миллионов человек будут умирать ежегодно из-за устойчивости к противомикробным препаратам, если не предпринять меры
Всемирная организация здравоохранения (ВОЗ) включила устойчивость бактерий в список 10-и наиболее серьезных угроз человечеству.
«PRO Здоровье» 19.01.2021 -
Лекарственные средства и препараты, медицинское оборудованиеСохраняя бесценный ресурс: Всемирная неделя правильного использования антибиотиков
В этом году с 18 по 24 ноября проходит Всемирная неделя правильного использования антибиотиков, целью которой является...
«PRO Здоровье» 18.11.2020 -
Лекарственные средства и препараты, медицинское оборудованиеЭволюция супермикробов: как мировая медицина теряет возможности для лечения инфекций
Распространение антимикробной резистентности (АМР) вызывает беспокойство представителей медицинского сообщества по всему миру. Продолжающиеся потери эффективных средств борьбы...
«PRO Здоровье» 09.10.2020 -
Лекарственные средства и препараты, медицинское оборудованиеНано-пленки нитрида бора заменят антибиотик при защите от бактериальных и грибковых инфекций
Материаловеды НИТУ «МИСиС» представили антибактериальные нано-покрытия на основе нитрида бора, обладающие высокой эффективностью против микробных патогенов –...
«PRO Здоровье» 09.09.2020 -
ЗаболеванияЭксперименты с бактериями в космосе позволяют изучать образование биопленок
Данные эксперименты основаны на уникальной технологии формативной биофабрикации с использованием магнитной седиментации.
«PRO Здоровье» 11.03.2020 -
Лекарственные средства и препараты, медицинское оборудованиеВсемирная неделя правильного использования антибиотиков. Антимикробная резистентность – личная ответственность каждого?
В настоящее время по причине антимикробной резистентности погибают порядка 700 000 человек в год.
«PRO Здоровье» 12.11.2019 -
ЗаболеванияПрием антибиотиков: как избежать дисбактериоза
При простуде прибегать к антибиотикам не только бесполезно, но и вредно. Важно не принимать вместе с антибиотиком...
«PRO Здоровье» 16.10.2017 -
ЗаболеванияВ горло по грибы
«Замучили ангины, уж чем я только не лечусь, а все без толку», – жалуются многие. Вот удивились...
«PRO Здоровье» 06.12.2010
-
Мир звуков: простые шаги к лучшему восприятию речи и музыкиЗаболевания25.03.2022
-
Невидимые болезни под прицелом: как МРТ находит опухоли на ранней стадииЗаболевания27.03.2022
-
Кодирование от алкоголизма: особенности процедуры, разновидности и преимуществаЗависимость, вредные привычки31.03.2023
-
УЗИ печени: когда проводится и для чего необходимоЗаболевания19.05.2022
-
Уколы красоты: 10 самых популярных и эффективных инъекционных процедурКосметология19.05.2022
-
Ночные линзы для восстановления зрения — сколько стоят?Лекарственные средства и препараты, медицинское оборудование16.04.2022
-
Когда можно мочить брови после перманентного макияжаКосметология22.12.2021
-
Как защитить себя и своих близких от ротавирусной инфекции и не испортить летний отдыхЗаболевания20.07.2021
-
Как отличить родинку от папилломыЗаболевания29.10.2021
-
В России наблюдается серьезный дефицит медицинских психологовПсихология и здоровье23.11.2021
-
Основные правила хорошего петтинга.Он и Она01.07.2024
-
Врач «Инвитро» рассказал, как правильно начинать заниматься спортомАктивный образ жизни30.09.2021
-
5 простых советов, которые помогут привлечь внимание на сайте знакомствОн и Она27.04.2022
-
Исполнился год со дня регистрации в России препарата «Дантролен», спасающего от злокачественной гипертермииЛекарственные средства и препараты, медицинское оборудование03.03.2023
-
Болезни на кончике щетки: эксперт о том, как зубной налет разрушает весь организмСтоматология18.06.2026
-
Эксперт объяснил, чем на самом деле опасен тополиный пухОкружающая среда18.06.2026
-
Хранение продуктов в пластике: химические опасности по оценке экспертаЕда, продукты питания18.06.2026
-
Патологическое и физиологическое головокружение: важные разъяснения экспертаЗаболевания18.06.2026
-
Эксперт предупреждает: чем опасны сухие завтраки для детейЕда, продукты питания18.06.2026
-
Как выбрать дебетовую карту и получать от неё реальную выгодуСправочник17.06.2026
-
Эксперт рассказал, когда боль в суставах нельзя считать нормойЗаболевания17.06.2026
-
Оптимальный возраст первой беременности: рекомендации ассистента Пироговского УниверситетаБеременность17.06.2026

Odnoklassniki
VKontakte
Telegram
RSS